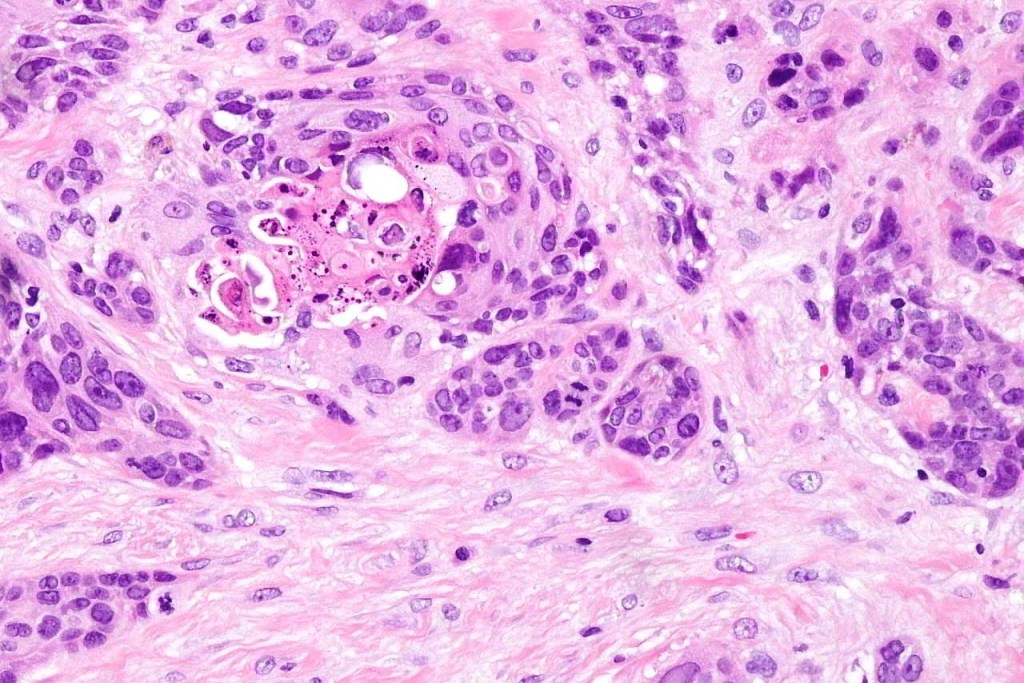
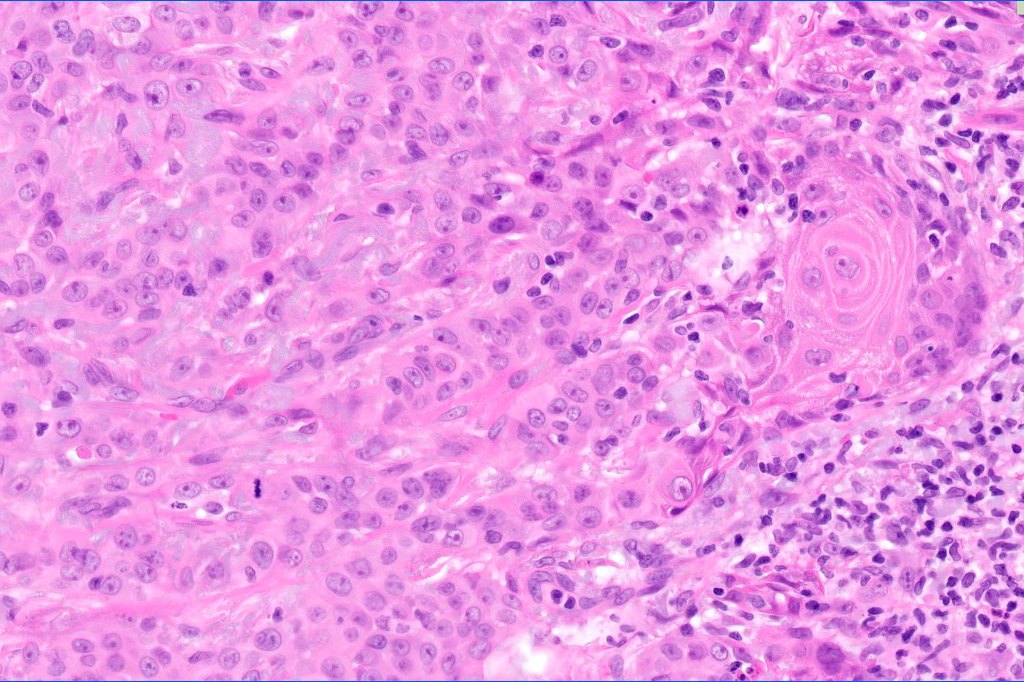
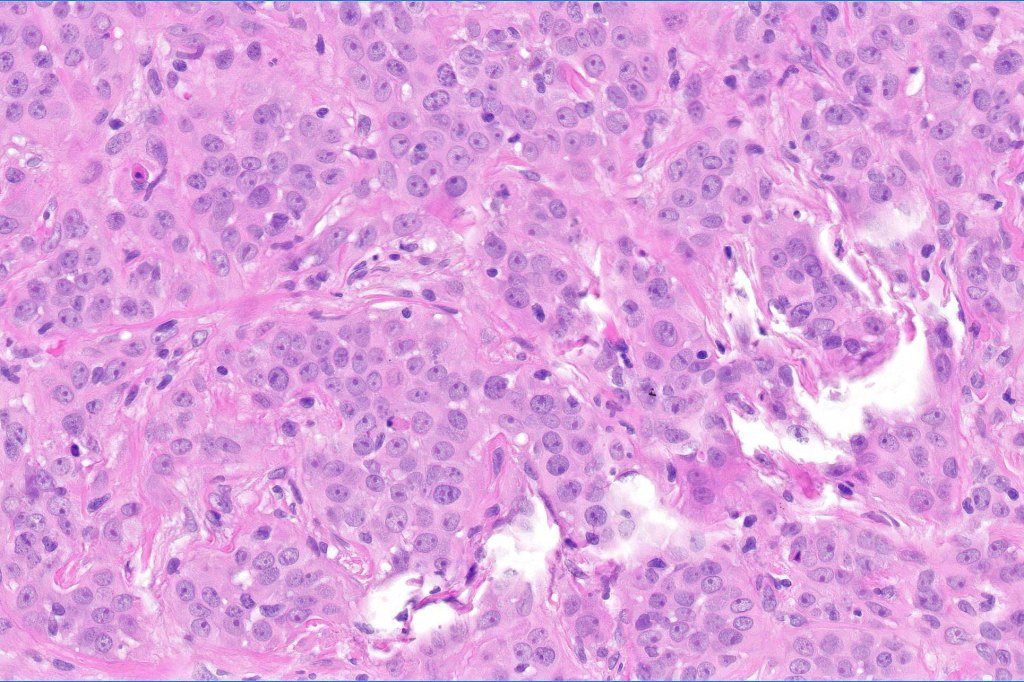

Clinical features
•Exceedingly rare tumor comprising squamous cell carcinoma (in the superficial part) and adenocarcinoma in the deeper reaches. Often misdiagnosed in shave biopsies & sometimes confused with microcystic adnexal carcinoma
•Middle aged to elderly patients
•Slight predilection for males
•Head, neck & extremities on sun-damaged skin
•Recurrences common, may spread to lymph nodes or systemically & can rarely cause death
Histological features
•Ulceration and solar elastosis are common
•Widely infiltrating biphasic tumor
•Superficial SCC
•Adenocarcinoma in deeper reaches
•Variable pleomorphism and mitotic activity
•Deep part may show both ducts and glands
•Often extends to the subcutaneous fat
•Perineural infiltration is commonly seen
Immunohistochemistry
•BerEP4, MOC 31, cytokeratin 7, cytokeratin 5/6, EMA & CEA +ve
•P63 +ve

Differential diagnosis
•SCC is the most common differential diagnosis when superficial biopsies miss the glandular component
•Microcystic adnexal carcinoma is sometimes confused with syringoid eccrine carcinoma. The former shows superficial keratocysts in the absence of SCC and in the deeper reaches, the epithelium is well differentiated & shows intracytoplasmic lumina and occasional well-formed ducts embedded in a dense fibrous stroma. Glands are not a feature
•Eccrine ductal carcinoma is composed of an adenocarcinoma throughout
Leave a comment